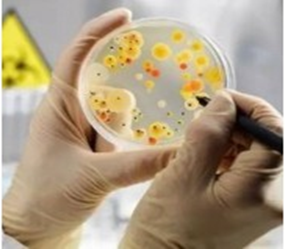

13个回答
我们看到“生物科学”和“生物学”就知道,这两个名词肯定是不一样的,因为字不一样啊,那么具体的区别有哪些呢,让我们来看一下~

生物科学的研究主体肯定是生物啦,但主要是各种生物的一些基本的生命规律,不同的生物研究有植物学、动物学、遗传学等。需要实验技术与理论知识相结合。
比如,在日常学习中,生物科学的同学在学习微生物的时候,会去实验室进行动手操作,通过从室外采集所需要的土样,利用土壤稀释法进行浓度梯度设置,最后配置不同的培养基,倒平板,平板划线法接种不同的种群等,进行菌种的初筛选,再利用复筛菌种,最终可以得到自己想要的纯种菌株。
结合课堂上的理论知识,就会更加简单易懂。而且容易记住。生物科学还会进行野外实习,比如我们本科野外实习,集体去了山里面的一个小村子住了一周,白天就随着带队老师去山里面采集植物,下午回来就制作标本,了解这些植物的名称和生长地。

而生物学,在我看来更像是一个大类,一个综合体。可以涉及很多相关内容,主要研究生物就是我们常见的植物、动物、微生物等。生物学会具体的研究某一个生物的器官、结构、生理。知识会比较细,比如病毒、原核生物、真核生物的特点,以及这几个大类下面的具体例子和结构功能,所以需要了解很多具体的知识。
其实生物很多专业名字有差别,但是真正学习的知识还是有类似的,所以按照大类的不同选择适合自己的生物专业是最好的。
生物科学专业在读生亲答
生物学和生物科学就差了一个字“科”,其实就体现在科学这个差别上。
那什么是科学呢?
科学是指一个建立在完整的、能够经过实践检验或者通过一系列合理演算推测出对于客观事物描述形式的系统方法。放在生物学和生物科学上来说,可以简单理解为生物科学是人们所要经过初中、高中、本科、研究生、博士所学习的传统生物学学科的所有知识,而生物学只是像物理学、化学、英语、语文这样一个学科的名称,所以在之前高校改系为学院的时候,很多高校都是由XX大学生物系改为XX大学生命科学学院,因为生物学这个词并不能体现出该学科是要有科学发展的历程和必要性。

那么生物科学对于想问这个问题的你来说要怎么解释呢?
首先,如果你作为高考考生来说,生物科学这是一个可能即将学习的专业,这是和物理学等相同的一个传统自然科学的专业,要想学好生物科学这个专业就得要经过之前所说的中学、本科、研究生甚至博士这些传统学科培养人才的必经历程,要学习基本的动物学、植物学、微生物学、生态学、分子生物学、系统分类学等等这些基本科目才算是入了生物科学的门槛,到了研究生阶段选择自己的研究方向,继续在这个方向上开展自己的研究,这就算是上了生物科学的道路上来了。

生物学为什么和生物科学有区别呢?
生物学之所以没有称之为生物科学,就在我所说的科学要建立在一个完整的客观描述事物形式的系统方法,生物学是还没有入门到科学的普通生物知识,它还没有经过一系列科研研究,或者完整的、先进的科研研究的生物知识。就像高中课本是叫做生物学,而进入到大学,就是生物科学了。
最后,如果你还有什么想要交流的地方都可以在评论区留言哦~我会为大家仔细讲解的哦~
作为生物学研究生的我来说一下我对这两者的看法。
生物科学和生物学仅有一字之差,重点在于科学与学。
科学是一个统称,主要探究正确的,存在的真理。例如我们常说的科学家,多代表的是搞研究的一大类人,无论做哪些研究 。学代表的学派,代表的是一条条研究的路线。
1.生物科学代表的就是在生物领域的科学类的研究,探究的是生物的内在规律,生物包含我们常见的动物、植物,以及看不到的细菌病毒,属于生物范畴的都是他们的研究对象。
具体到大学本科专业,在教育部《专业目录》的理学门类下设有生物科学类,下设生物科学、生物技术、生物信息学和生态学四个专业。四个专业学习内容有所区别,但探究的还是生物领域的原理知识。
生物科学专业的学习内容众多,这些都代表了生物科学的范围,它们的任意一个知识都可以说代表了生物科学。但是也可以看出,生物科学包括的不仅仅是生物的知识,还有计算机等方方面面的应用,就像这个生物信息学,是目前生物的大热门,也许多年以后,电影中的基因芯片会真正降临。

目前生物科学仍处于发展状态,无论是微观还是宏观,我们对生物科学的探究还需要继续。。
2.生物学英文为Biology,是自然科学六大基础学科之一。研究生物的各种情况,包括结构、功能、生长繁殖。无论有没有规律,都属于生物学。
生物学是一级学科,它代表的也是学科的综合,即你做的是什么方面,不像还科学一般上升到规律及正确的认知。生物学较生物科学代表的是方向。

所以,可以将生物科学理解为一个类别,包含和生物有关的各类现象规律,可能含有物理、化学和医学等多个方面的,代表了大家都共同认知。而生物学就是学科,包含的是不同方向的生物的研究,不讲究对错。
东北农业大学大二学姐路过~大家都有这种经历,就是高考毕业填报志愿专业的时候,看到了许多看起来很类似的专业,比如生物技术、生物工程、生物学、生物科学等等。其中生物学和生物科学在名词上只差了一个字,没有学过生物类专业的人可能觉得这两个词听起来没什么大的不同啊,那么它们到底区别在哪里呢?

说说我自己的理解吧,首先说生物学,初中、高中大家都有学习过生物,大学的生物学学习内容是高中的深化,但再深化,也是人类目前已知的生物方面的知识,比如生物学专业的同学要学习细胞、分子、基因、遗传等。而生物科学呢,主要在于他的“科”字,它属于一个以培养科研人才为主的专业,生物科学专业的同学要学习生物化学,生态学,植物生理学,细胞生物学,微生物学,解剖学,遗传学等等。悄悄说一句,大学流传着一句话叫做生理生化必有一挂,这也是学长学姐流传下来的啦,意思是生理学和生物化学不好学,但是又极为重要,所以以后要学生物科学专业的小可爱们要在这两科上多下功夫哦~(附上一张中国科学院生物研究所的照片,这可是多少学子的向往~)

不管你学习生物学还是生物科学,总之大学就更加细致深入,比如光合作用,呼吸作用啥的就要学习它的整个化学转变过程,你要熟练掌握非常细致的每一步反应,你结合自己的书本学习要有能力设计自己的实验。这两个学科有一个共同之处就是要想学好它们,就要下功夫背,下功夫记书,如果是在东北农业大学的话,学姐也考过生物科学专业的专业课考试,只要背好,分数什么的绝对不低。当然啦,你们可不要光背书哦,一样需要理解才能学的更好。

看到这里你是不是对生物学和生物科学有了一定的了解?至少已经能轻松的把它们的研究领域分开了吧,欢迎大家向我提问,只要是我知道的一定尽力解答~
高途徐京生物秋季班(高清视频)百度网盘
链接: https://pan.baidu.com/s/1LGtCgMu7LmAx6mJFbbNnnQ
若资源有问题欢
